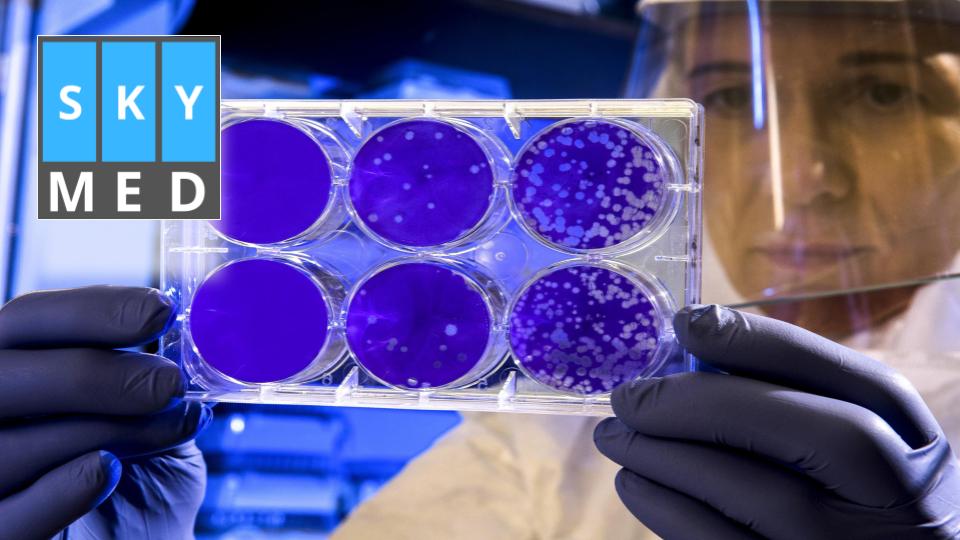
Acompañamiento emprendedores

El proyecto se denomina “SkyMeD” y es uno de los 10
emprendimientos
ganadores de la Hackaton PAE 2020. Recibió el acompañamiento por parte
del Municipio y consiste en un Sistema de Relevamiento, Monitoreo y
Gestión digital de datos para Instituciones de Salud y entidades de
control que llevan adelante el control de personas en Aislamiento Social
Obligatorio (ASO), ante la presencia de COVID-19.
Cecilia Carrizo y Daniel Marcellino crearon una aplicación que se
convirtió en uno de los diez proyectos ganadores de uno de los eventos
más importantes del año, la Hackaton PAE.
El proyecto se llama SkyMeD y recibió acompañamiento y asesoramiento por
parte de la Municipalidad de Comodoro Rivadavia a través de la Agencia
Comodoro Conocimiento y su Oficina de Apoyo a Pymes y Emprendedores en
el marco de la pandemia.
El emprendimiento consiste en un Sistema de Relevamiento, Monitoreo y
Gestión digital de datos para Instituciones de Salud y entidades de
control que llevan adelante el control de personas en Aislamiento Social
Obligatorio (ASO), ante la presencia de COVID-19.
La aplicación permite que las entidades cuenten en tiempo real con
información estratégica para activar sus protocolos en forma inmediata.
“Queremos ayudar a agilizar el trabajo a muchos médicos y poder dar un
mejor servicio a todos los ciudadanos afectados por esta pandemia.
Incluso el uso de nuestro desarrollo puede ser adaptado post pandemia al
trabajo con otras enfermedades como Hanta Virus y Dengue, o de plagas
como la Mosca de la fruta”, explica Cecilia Carrizo, una de las
creadoras del proyecto.
Ellos viven en Lago Puelo y tienen una empresa desde hace dos años que
se llama “SkyDron” dedicada al relevamiento y monitoreo digital de
sistemas de información a través de drones para distintos rubros.
Cuando apareció la pandemia, les pareció una buena idea realizar una
acción de Responsabilidad Social Empresaria para colaborar con la
situación y se pusieron manos a la obra.
El 29 de abril comenzaron la carga de datos y se aventuraron en elaborar
un sistema de monitoreo similar para Defensa Civil que informa en tiempo
real a cada hospital de la zona, las personas que deben ser ingresadas a
aislamiento, lo cual permite iniciar los protocolos de forma urgente,
sin perder tiempo.
Hoy, son uno de los diez finalistas de la Hackaton PAE, un evento que
organiza la empresa Pan American Energy junto a SocialLab, Provincia del
Chubut y que es apoyado por el Municipio de Comodoro Rivadavia, Comodoro
Conocimiento y otras organizaciones, en el que participaron más de 200
proyectos de emprendedores de todo el país y del mundo, y donde gracias
a su emprendimiento, participarán de una Bootcamp Post Hackaton
(Aceleración) en el que van a prototipar sus soluciones para el contexto
Covid19.
Hoy, con el emprendimiento que crearon están trabajando con Defensa
Civil y el sistema está funcionando para los hospitales de Lago Puelo,
El Hoyo, Cholila, El Maitén y Epuyén; junto a Bomberos Voluntarios,
Defensa Civil del Municipio y el área de Bosques de la zona están
armando un sistema de relevamiento de familias en riesgo de inundación y
otro proyecto con la Universidad Nacional de la Patagonia San Juan Bosco
de Comodoro Rivadavia para
un desarrollo tecnológico para plagas.
“Estamos muy agradecidos por esta oportunidad que nos están brindando y
poder seguir adelante con todo lo que estamos creando como empresa.
Estos pasos y esta caricia al alma de ser uno de los ganadores de la
Hackaton, es también el reconocimiento y un `gracias enorme’ a cada una
de las personas y entidades que siempre nos apoyaron como: Agencia
Comodoro Conocimiento, Ministerio de Agricultura, Ganadería, Industria y
Comercio de Chubut, CIMA, CAMEETIC, PAE, Sociallab, Ministerio de
Desarrollo Productivo de Nación y Mayma, entre tantos otros. Gracias a
ellos se generó una red de contención donde uno es también parte de esa
red y puede ayudar a otros a emprender”, finalizó la creadora de SkyMed.
Para consultas sobre el emprendimiento, comunicarse vía correo
electrónico a: info.skydron@gmail.com



